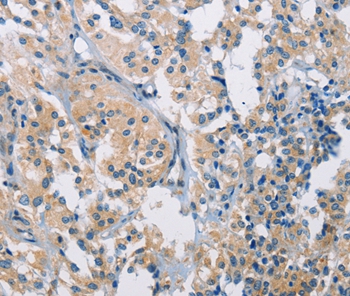

Programmed Cell Death Protein 1 Ligand 2 (PDL2) Polyclonal Antibody
CAU27135
ApplicationsImmunoPrecipitation, Western Blot, ImmunoCytoChemistry, ImmunoHistoChemistry
Product group Antibodies
TargetPDCD1LG2
Overview
- SupplierBiomatik
- Product NameProgrammed Cell Death Protein 1 Ligand 2 (PDL2) Polyclonal Antibody
- Delivery Days Customer12
- ApplicationsImmunoPrecipitation, Western Blot, ImmunoCytoChemistry, ImmunoHistoChemistry
- Applications SupplierWB; IHC; ICC; IP.
- CertificationResearch Use Only
- ClonalityPolyclonal
- Concentration0.5 mg/ml
- ConjugateUnconjugated
- Gene ID80380
- Target namePDCD1LG2
- Target descriptionprogrammed cell death 1 ligand 2
- Target synonymsB7DC, Btdc, CD273, PD-L2, PDCD1L2, PDL2, bA574F11.2, programmed cell death 1 ligand 2, B7 dendritic cell molecule, B7-DC, PD-1-ligand 2, PDCD1 ligand 2, butyrophilin B7-DC, programmed death ligand 2
- HostRabbit
- Protein IDQ9BQ51
- Protein NameProgrammed cell death 1 ligand 2
- Scientific DescriptionThe Programmed Cell Death Protein 1 Ligand 2 (PDL2) Polyclonal Antibody (Species: Human) has been validated for the following applications: WB, IHC, ICC, IP.
- Reactivity SupplierHuman
- Storage Instruction-20°C,2°C to 8°C
- UNSPSC12352203